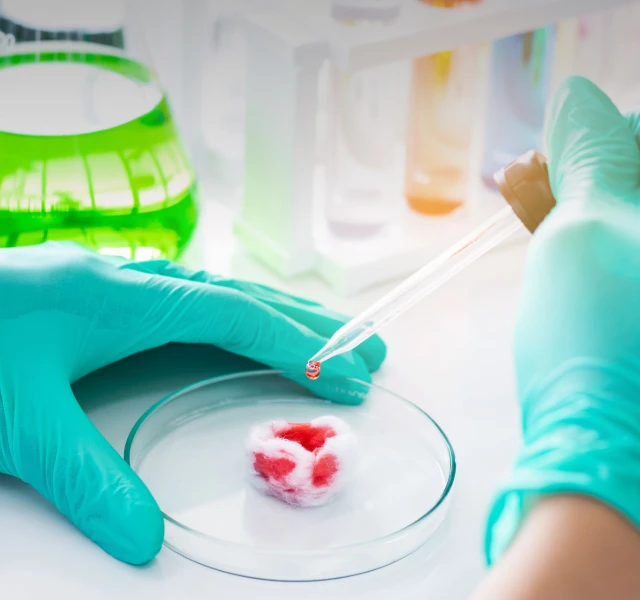
Industrial protection gloves used in chemical industry environments for handling chemicals, industrial liquids, and routine processing tasks.

Best Way to
Protect Industrial Workers
Industrial work is demanding. Hand protection should be built for it.
INTCO Medical provides engineered industrial protection gloves designed for exposure to chemicals, oils, abrasion, heavy tools, and long working hours—helping teams work safely with confidence and control.
Choose the Glove That Fits Your Task
| Pictures | Product Type | Thickness | Key Protection | Grip Level | Comfort & Dexterity | Best For | Color Options |
|---|---|---|---|---|---|---|---|
|
|
Diamond Textured Nitrile Gloves | 5–8 mil | High grip + puncture & tear resistance |
5/5
|
4/5
|
Automotive repair,
machinery handling, workshop use |
Orange / Black |
|
|
ChemTuff™ Disposable Nitrile Gloves | 3.5–6 mil | Chemical resistance + EN 388 abrasion level 2 |
3/5
|
5/5
|
Lab work, coating, electronics, chemical handling | Green |
|
|
Biodegradable Nitrile Gloves | 3–6 mil | General chemical splash + anaerobic landfill biodegradation |
3/5
|
4/5
|
Manufacturing, general maintenance, daily industrial tasks | Blue / Green |
|
|
Disposable Nitrile Gloves (9") | 3.5–6 mil | Puncture resistance + light chemical splash protection |
4/5
|
4/5
|
Automotive refinishing, cleaning, maintenance | Blue / Black / Orange |
|
|
Disposable Nitrile Gloves (12" Extended Cuff) | 3.5–8 mil | Chemical splash + extended wrist & forearm coverage |
4/5
|
4/5
|
Electronics assembly, laboratory work, industrial cleaning | Blue |
|
|
Synmax Vinyl Disposable Gloves | 3-3.5 mil | Abrasion-resistant (up to 10× stronger than nitrile gloves) |
3/5
|
3/5
|
Light manufacturing, machine operation, daily industrial work | Blue / Black |
Certifications & Standards
Trusted industrial hand protection, verified by internationally recognized safety and performance standards
Industries We Serve
INTCO Medical industrial gloves support safe and efficient operations across a wide range of industrial environments
Get Started with INTCO Industrial Protection
Connect with our team to discuss your industrial glove requirements and receive tailored product recommendations.
-
 WhatsApp: +86 18810016133
WhatsApp: +86 18810016133 -
 Email: glove@intco.com
Email: glove@intco.com